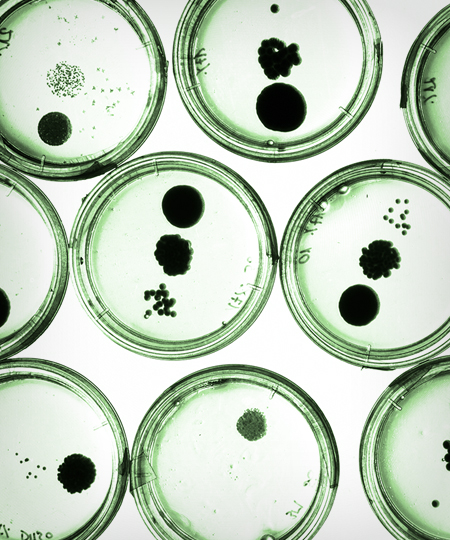

BRAND
Wonfer Peptide Complex
피부에 핵심적인 5종류의 성장 인자와 피부의 젊음에 도움을 주고
피부 자생력에 도움을 주는 펩타이드 복합체입니다.

EXOHEAL INGREDIENTS
Hair Skin Biome(H)
10~20대의 두피에서 분리한 독자 신규 미생물(Leuconostoc GFC1203H)로
피부의 특정 유해균을 억제하고 피부 유익균의 다양성을 증대시켜 주어
항산화 및 항염증, 비듬균을 억제하여 건강한 두피 관리에 도움을 줍니다.
또한, 육모 효과로 모발의 생성을 유도하고
모유두 세포의 활성화로 성장기에 해당하는 모발의 수를 증가시켜
풍성한 모발 관리에도 도움을 줍니다.
※모유두 세포란 모근 끝에 위치한 세포로 영양분을 모발로 끌어올리는 '모발의 씨앗'
[특허출원] 제 10-2020-0171272호 뉴코노스톡 홀자펠리 GFC1203H 균주 및이를 이용하여 제조된 발효물
※원료적 효능에 한함

Haregrow™(H)
베트남 콩과식물 “Dalbergia Oliveri”에서 발견한 탈모케어 원료로
모낭 조직을 이용한 탈모치료 연구에 저명한 연세대 약대와
자사 내츄럴 바이옴 연구서 공동 개발한 자사 내츄럴 바이옴 독점 탈모케어 소재입니다.
“Dalbergia Oliveri” 는 베트남 전통의학에서 만성 궤양 치료용으로
사용하던 천연항셍제 Phytoalexin가 매우 풍부한 식물로 베트남, 미얀마, 태국등
동남아시아에서 분포하며 탈모 효능 소재로 최근 주목 받고 있는 원료입니다.
우수한 모발 성장 촉진 효과와 발모효과, 모유두 세포 활성화로 성장기에
해당하는 모발의 수를 증가시켜 풍성만 모발 관리에 도움을 줍니다.
※원료적 효능에 한함

Phyto 9 Stem Cell Complex
건강한 피부로 케어해 주는 9가지 핵심 식물 줄기세포 복합체.
1.인삼캘러스배양추출물, 주름개서 피부 탄력 등 다양한 효능을 발휘 하고, 진세노사이드(Ginsenoside)가 노화된 피부 세포의 재생을 도와 피부 탄력 부여 및 노화를 예방합니다.
2.에델바이스캘러스배양추출물, 항상화 작용으로 피부 미용에도 큰 효과를 주는것으로 알려지면서 세계 여러나에서 화장품의 원료로 사용 되고있습니다. 피부에 과다하게 전달된 자외선을 흡수해 피부 손상 및 피부 노화의 원이 되는 활성산소를 억제하여 피부 노화방지의 도움을 줍니다.
3. 사막장미캘러스배양추출물, 이스라엘과 요르단, 시나이등의 사막 지역이 원산지인 사막의 장미는 수십년동안 건조한 상태로 있다가 물이 닿으면 다시 피어나는 신비한 식물로 피부의 수분공급 및 전정에 도움을 줍니다
4.장미캘러스배양추출물, 기존 스템셀에 없는 Elicitor을 통해 효능을 극대화하는 Elicitor technology 적용하여 콜라겐 분해 효소가 뛰어나 주름 개선에 효과가 있습니다.
5.토마토캘러스배양추출물, 라이코펜, 베타카로틴 등 강력한 항산화 물질을 다향 함유하고 있으며, 노화의 원인인 활성산호를 배출시켜세포의 젊음을 유지하며, 자외선으로부터 피부를 보호합니다.
6.사과세포배양추출물, 케르세틴이나, 비타민C, 페놀산과 같은 강력한 항상화물질이 함유되어 활성산소를 억제해주고, 세포의 노화 및 조직 손상을 억제, 안토니아신 성분이 활성산소를 억제해주며 피부노화 방지에 도움을 줍니다.
7.라벤더잎세포추출물, 세포 재쟁 성분 함유로 피부 재생 촉진 및 트러블 예방, 피부 노화방지, 피부 진정효과가 뛰어나 자극 받은 피부를 가라 앉히는데 도움을 줍니다.
8.석류캘러스배양추출물, 타닌과 에스트로겐, 항산화 물질의 다량 함유로 피부노화를 방지하며 탄력 및 주름개선에 도움을을 줍니다.
9.포도세포추출물, 안토시아닌 성분이 활성산소의 활동을 억제해 피부 노화방지에 도움을 줍니다.
※원료적 효능에 한함

Baby Collagen 베이비콜라겐
인체에 존재하는 총 27종류의 콜라겐 중 하나로, 아기 피부에 가장 많이 존재하며
성인 피부에는 약 20% 정도만 존재하고 있습니다.
보통 태아의 피부에서는 콜라겐 타입 Ⅰ과 Ⅲ의 비율이 1:1로 동등한 비율로 존재하지만
나이가 들수록 피부 속 콜라겐 타입 Ⅲ의 합성 능력과 생성 능력이 떨어지면서 콜라겐 타입
Ⅲ의 비율이 현저히 감소하게 되고 이는 피부 결과 피부 탄성을 저하시켜 노화가 급격히 진행되게 됩니다.
베이비콜라겐 (Type Ⅲ Collagen)은 콜라겐 타입 Ⅰ과의 합성을 증가시켜 피부의 주름을 개선시키는 데 도움을 줍니다
※원료적 효능에 한함

Guaiazulene 구아이줄렌
구아이아줄렌은 땅에서 나는 사과라는 뜻을 가진 이름의 허브인 캐모마일의 오일에서 얻은
천연성분으로 아줄렌의 유도체입니다.
캐모마일은 유럽, 북아프리카, 북아시아가 원산지이며, 달콤하고 상쾌한 사과향을 지녀 차로
즐기거나 목욕, 미용 등에 이용됩니다.
짙은 푸른색을 띠고 있어 미국 FDA에서 승인한 화장품용 착색제로도 사용되고 있습니다.
구아이아줄렌은 민감하고 예민해진 지친 피부를 진정시켜 건강한 피부로 개선하고
관리하는 데 도움을 주고 피부를 보호하는 데 도움을 줍니다.
※원료적 효능에 한함

Triple Layer Moisture Liposome
트리플 레이어 모이스처 리포좀
Glycerly Glucoside
※원료적 효능에 한함
아프리카 사막에서 살아남는 부활초의 주성분으로 건조하고 높은 자외선의 환경에서도
식물의 활력 세포가
유지될 수 있도록 도와주는 ‘글리세릴’ 과
‘글루코오스’ 의 천연결합물 입니다.
일반적으로 피부 보습 성분으로 많이 사용되는 글리세린보다 안전한 성분으로 자체
방부력이 뛰어나 방부제가 필요 없는 천연 보습제로서의 역할을 합니다.
Sodium Hyaluronate
※원료적 효능에 한함
피부에 일정량 존재하는 천연보습인자로 주변의 수분을 끌어당겨 흡수하고 저장하는
역할을 함으로써 피부의 보습을 유지시켜 줍니다.
Adenium Obesum Leaf Cell Extract
(사막장미잎세포 추출물)
※원료적 효능에 한함
사막장미는 수분 저장고 성분으로 주목 받고 있으며 고온 건조한 사막지대인 예멘의
아덴에서 최초로 발견되어 사막의 오아시스라고도 불립니다.
극심하게 건조한 기후 속에서도 놀라운 저항력으로 수분을 유지한 채 살아남는 식물로,
수십년 동안 건조한 상태로 있다가 물이 닿으면 다시 피어나는 강인한 생명력을 가지고
있습니다.
사막장미잎세포추출물은 피부에 풍부한 수분을 공급해 피부에 탄력을 주는 등 노화 방지에
도움을 줍니다.